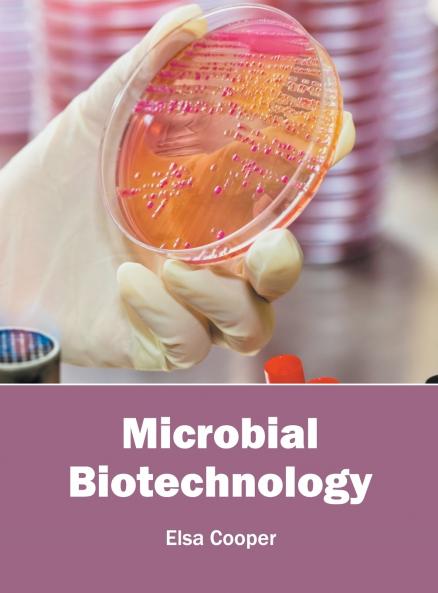
Microbial Biotechnology

English
Hardback
₹13787
(All inclusive*)
Delivery Options
Please enter pincode to check delivery time.
*COD & Shipping Charges may apply on certain items.
Review final details at checkout.
Looking to place a bulk order? SUBMIT DETAILS
Delivery Options
Please enter pincode to check delivery time.
*COD & Shipping Charges may apply on certain items.
Review final details at checkout.
About The Book
Description
Author
Microbial biotechnology is an interdisciplinary field of study that incorporates concepts and techniques of microbiology and biotechnology to develop useful products. The topics covered in this extensive book deal with the major applications of microbial biotechnology in drug development food processing biocatalysis etc. The ever growing need of advanced technology is the reason that has fueled the research in this field in recent times. The chapters included herein are appropriate for students seeking detailed information in this area as well as for experts.
Details
ISBN 13
9781682860977
Publication Date
-24-05-2016
Pages
-218
Weight
-677 grams
Dimensions
-216x280x14.29 mm